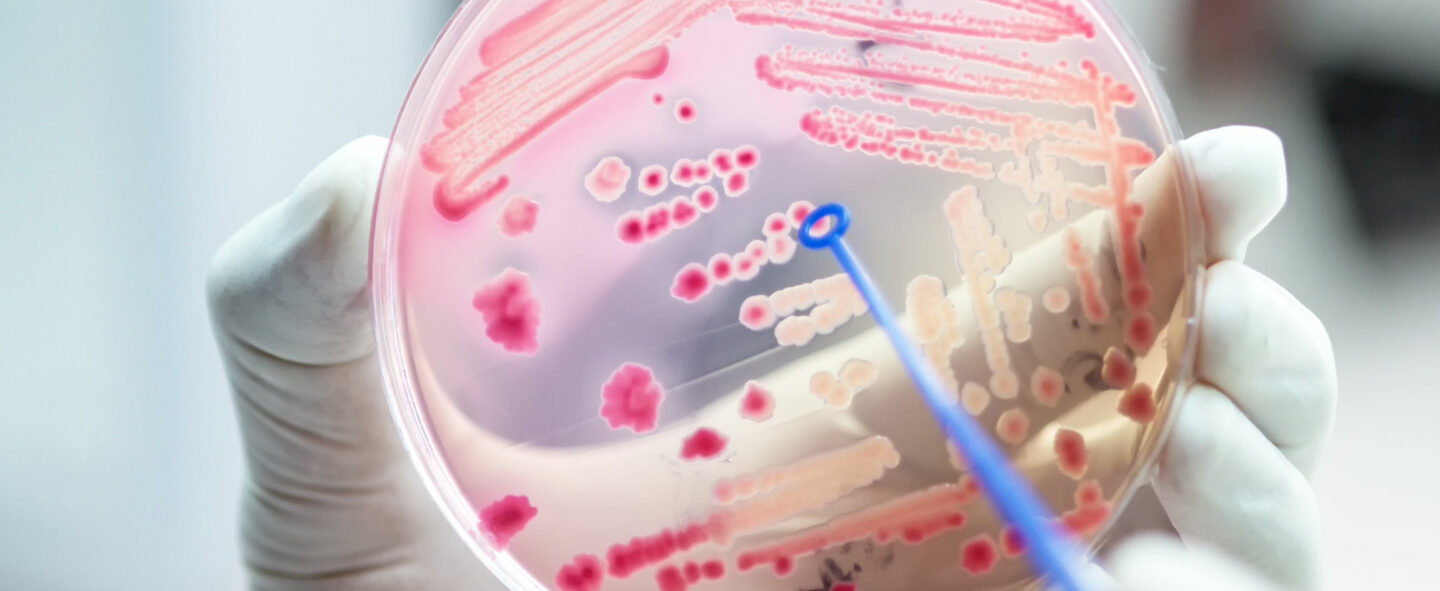

Dr. Lena Robra
Pharmacogenomics: What does this mean for your health?
Modern medicine is saving millions of lives every year. Nonetheless, even if a given drug helps others, it may not be the right choice for you. Or, you may experience serious side effects while someone else does not.
Your age, lifestyle and many other factors influence your response to medications. You know what else is a critical factor? Your GENES! And this is exactly what Pharmacogenomics examines – how your genetic makeup influences the way you respond to drugs, helping you make more informed decisions. The future of personalized / precision medicine lies in administering therapies that are uniquely suited to each patient.
Progress in pharmacogenomics relies heavily on, you guessed it, open dialogues and peer learning. Our Indo-Swiss symposium is one such platform bringing the brightest minds from Switzerland and India. Switzerland, renowned for its medtech, biotech and pharma research, and India, with its rapidly growing medtech innovation space and the relevance of a unique population, make excellent partners in creating ground-breaking solutions in this field.
Join us for the Indo-Swiss expert exchange on Pharmacogenomics, and connect with eminent scientists and clinicians from Switzerland’s CANSEARCH along with Indian experts. Explore this excellent opportunity for the healthcare professionals, medical students, faculty, scientists from industry, academia and regulatory bodies to stay ahead of pharmacogenomics research and trends, in various fields of medicine.
The expert exchange will be on the topic of Impact of Pharmacogenomics in Achieving Personalized Medicine / Precision Medicine in Clinical Settings.
Meet the speakers:
This Indo-Swiss symposium is a part of Symposium on Pharmacogenomics (Module-3) under the JIPMER Integrated Pharmacogenomics Program (JIPP-2022) organised by the Department of Pharmacology, JIPMER, Puducherry.
Dr. Lena Robra